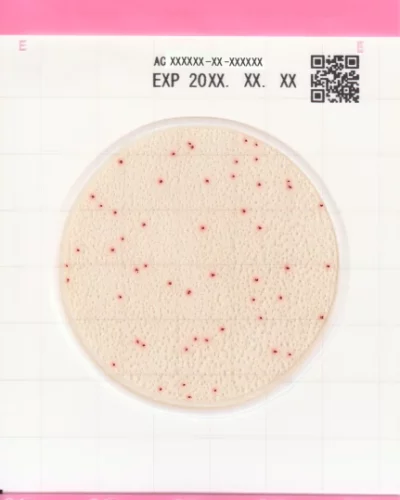
Easy-Plate-AC

EASY PLATE AC
Aerobik Bakterilerin Gelişimi İçin Özel Besiyeri
Easy Plate AC, aerobik bakterilerin sayımı için AOAC sertifikalı özel, hazırlık ve sterilizasyon gerektirmeyen, hazır ve steril bir besiyeridir. Kolayca ayırt edilebilen renkli kırmızı koloniler sağlayan bir kimyasal indikatör içeren mikrobiyal test kiti, aerobik bakterileri 48 saat içinde kolayca tanımlayıp saymanızı sağlar. Easy Plate AC, AOAC PTM sertifikalıdır ve her biri 25 test içeren 4 ayrı poşette 100 testlik paketler halinde satılır. 2-8°C arasında saklanır ve uzun raf ömrüne sahiptir.
